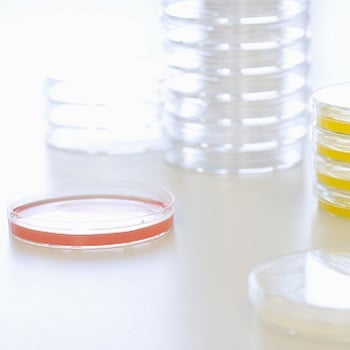

Company details for:
Cleanroom Supplies Ltd
Quick Links:
Products / Services

Alcohol Disinfectants
The 70% blend is used as a broad spectrum antimicrobial and it is rapidly bactericidal, fungicidal and virucidal. Whether you select IPA or DE is dependent on your use. If you need to know more about the differences between IPA and DE alcohol, please visit our Alcohol Selection Guide. The higher percentage water content makes the alcohol more efficient at killing bacteria.
Both products are available in sterile versions for cleanroom disinfection and wiping, and non-sterile. Our sterile products are gamma irradiated and double bagged for cleanroom transfer.

Cleanroom Packaging
Clear LDPE bags can be used for safe storage and handling of items in a cleanroom environment. They are ultra clean high barrier packaging, protecting against particulate contamination or chemical leaching.
Metallised moisture barrier bags offer extra protection by creating a barrier against oxygen, water, vapour, light and aroma.
ESD moisture barrier bags are similar to the standard moisture barrier bags, but provide ESD protection, making them suitable for keeping elecronic components dry and storing static sensitive devices in humid environments.

Disinfectant Wipes
Crystel Titanium wipes are rapid-action, sterile, sporicidal disinfectant wipes, specifically for surface disinfection in controlled cleanroom environments & aseptic areas as recommended by the NHS. They can be used on non-product contact surfaces such as workbenches, shelves, equipment, printers, and surfaces outside the Laminar Air Flow cabinet (LAF) for sporicidal disinfection and as part of a rotational regime.
AGMA Sterile pouch wipes are a high quality 70% Isopropanol or isopropyl alcohol (IPA) in water for injection quality water (WFI). All products use European Pharmacopeia grade alcohol blended with WFI quality water to guarantee endotoxin levels. A premium quality product suitable for use in all cleanrooms. Packed in a triple laminate, re-sealable foil bag which is easy to open and close whilst wearing gloves.

Dispensers
Cleanroom Supplies offer a range of dispensers for disposable products such as hairnets, shoe covers and gloves. All our stainless-steel dispensers are manufactured from 304 quality stainless steel. The wall mounted hygienic PVC plastic apron dispenser is lightweight and durable.
Here at Cleanroom Supplies we can create Bespoke furniture if the standard cleanroom furniture is not what you were looking for. We will work with you and design the furniture you want - and best of all this service is Free! We will produce CAD drawings of your requirements. When you are happy with the design we will manufacture, and deliver the furniture or bespoke fabrication for you.

Gloves
Not sure on the type of disposable glove to choose? Download our Free PDF Disposable Glove Selection Guide or Click here for Disposable Glove Sizing Assistance
If you have latex allergies, the Nitrile is superior quality and are safe to use by Latex sensitive individuals. Find out the facts about Latex Allergy in our Blog: Latex Allergy − Facts You Need To Know. Since the Nitrile gloves are free from natural latex, they are safe for use by latex sensitive individuals. Our Nirile gloves are made from a synthetic, nitrile rubber. The blue and purple nitrile material provides an added degree of durability compared to Latex. Our gloves have an ambidextrous design with a rolled cuff for extra strength. The gloves are strong, smooth amd soft. Vinyl gloves are more suited for food preparation and serving applications.

Hand Sanitising

Laboratory Coats
The laboratory coat material allows the skin to breathe while resisting the penetration of many non-hazardous liquids and particles. Our laboratory coats are manufactured from 53g microporous material, the same material as our Optimum Type 5&6 coveralls. The garments have a high quality front zip and have comfortable latex free knitted cuffs.

Mirrors
Cleanroom Supplies stock a completely shatter proof mirror made from quality 304 grade stainless steel, the mirrors are strong, resistant and hygienic. Suitable for a variety of applications such as cleanroom and food production. The mirrors are a highly polished stainless steel which can have pre-drilled holes and screws and come in a variety of sizes.

Mops & Mop Covers
Your cleanroom deserves better than a half-prepared solution. Prevent cross-contamination and ensure a clean, sterile working area with our purpose-designed mop systems.
Everything from our trolley buckets and wringers through to the mop heads are part of a series of designs built for the needs of a sterile work environment. The cleanroom isolator tool is perfectly designed for medical isolator and safety cabinet disinfection.

Cleanroom Paper
Cleanroom Supplies stock a specialist cleanroom paper. It is made with exceptionally pure cellulose to minimise contamination. A specialist coating is then applied, minimising particle and fibre release.
This paper is designed for use writing, copying, and printing within controlled environments. It is compatible with all standard printers and photocopiers. Next day delivery is available.

Cleanroom & Laboratory Chairs
Browse our range of cleanroom, laboratory and medical chairs. From chairs for static safe (ESD) environments to polyurethane posture stools, we offer an option to suit your industry needs. Suitable for many environments including cleanroom, lab, dental labs and where hygiene is a requirement.

Hair Nets
Decrease the risk of contamination by using the appropriate hairnets, mob caps and surgical caps. Cleanroom Supplies Ltd hairnets offer protection against both long and short hair in controlled environments. Cleanroom Supplies stock many types and colours of hair protection - for next day delivery.

Waste Bins
Cleanroom Supplies offer a range of cleanroom bins manufactured from high quality stainless steel and tough hygienic plastic. All our bins are appropriately colour coded for prevention of cross contamination.

Monitoring Equipment
Here at Cleanroom Supplies Ltd we carry monitoring equipment specifically for your cleanrooms and laboratories. Cleanrooms are required to have HEPA filters installed to reduce harmful particles. The DWYER® Magnehelic® Pressure Gauge is the recognised industry standard for accurate measurement of cleanroom and HEPA differential pressures.

Face Masks
Cleanroom Supplies Ltd stock a large range of PPE including Low Efficiency and High Efficiency Face Masks. All masks are in stock and available for NEXT DAY delivery.

Aprons
Here at Cleanroom Supplies, we offer disposable plastic aprons that are useful for many applications. This garment is made to protect you from spills and splashes. Plastic aprons are commonly used in nursing, healthcare and the food processing industry.
Laboratory Supplies & Consumables
Coming soon, a large selection of laboratory consumbables and supplies.
- Laboratory Supplies
- Consumables
- Petri Dishes
- Pipettes
- Test Tubes
- Autocalve Bags
- Cryo Vials

Neutral Detergent - Sterile & Non-Sterile
Cleanroom Supplies offer a range of quality, sterile and non-sterile, cleanroom neutral detergents. Our neutral detergents have highly effective surface cleaning properties with low foaming and low residue properties.

Recycle with Us
Since 2020, Cleanroom Supplies has managed a Recycling Service for our customers. You can be confident that used garments returned to us, will be handed responsibly with full audit trail.

Hygienic Cleanroom & Medical Keyboards and Mouse
One of the areas in cleanroom hygiene that is easily overlooked is that of the keyboards. It is very easy for dust and microbes to build up in the crevices between keys - and then dust and microbes can easily transfer to hands or gloves. View Cleanroom Supplies Ltd. range of hygienic keyboards for controlled environments and laboratories.

Medical Scrubs
Medical scrubs for NHS nursing and medical care and healthcare.
Top and bottom medical scrubs, offering comfort and durability at an affordable price. Each set features one top and one bottom, in a relaxed unisex fit.
The polyester/cotton scrub set blend is machine washable up to 60ºC.
Ideal for medical school students and a range of healthcare environments. Available in a range of colours. This product is the regular length.

Disposable Overshoes & Overboots
Those who manage cleanrooms or labs understand the importance of preventing any risk of contamination. Using the appropriate disposable shoe covers help maintain a sterile environment. We offer a range of disposable shoe covers, overshoes and boots to meet all of your needs.

High Purity (HPW) & Water For Injection (WFI)
Cleanroom Supplies stocks a range of sterile, high quality and high purity water products. Water for injection (WFI) is 0.2 micron filtered and Gamma irradiated for sterility. Supplied double bagged for cleanroom transfer and is available in trigger spray and 5 Litre format.

Particle Counter
Our particle counter is ideal for on the spot regular checks and environmental monitoring within your cleanroom. It is well designed, user-friendly and easy to configure. The hand-held Particle Counter comes complete with full validation certificate and carry case. The ISO/GMP cleanroom hand-held particle counter complies fully with the latest revision of ISO14644. Suitable for ISO and GMP cleanrooms.

Multi Layer Tacky Decontamination Mats
Removing contamination before the entrance is essential to keeping you cleanroom sterile. Whether you need a small, medium or large tacky mat, in white or blue, you will find it on our site. They can easily be secured to the floor near an entry or exit and can be utilised with our tacky mat floor frames.
About us
Cleanroom Supplies Ltd’s online store is your complete destination for cleanroom and laboratory essentials.
If you manage a controlled or hygienic environment, we understand your unique requirements—contamination control is at the heart of what we do. Our expertise ensures we can meet the highest industry standards, whether for pharmaceutical, research, or manufacturing applications.
We supply premium-quality disposable protective clothing from trusted brands such as Optimum Protection™ and Tyvek™, including sterile garments for pharmaceutical-grade cleanrooms. Alongside clothing, we offer an extensive selection of BPR-approved cleanroom disinfectants, including biocides, sporicides, and IPA alcohol wipes and sprays, to maintain strict hygiene and control contamination risks.
Our Products Include:
Cleanroom & Laboratory Chairs
Explore our selection of chairs designed for cleanrooms, laboratories, and medical settings. From ESD-safe seating to ergonomic polyurethane stools, we provide options tailored to your industry. Ideal for environments requiring hygiene, including labs, dental labs, and cleanrooms.
Hair Nets
Reduce contamination risks with the right hair protection, including hairnets, mob caps, and surgical caps. Cleanroom Supplies Ltd provides effective coverage for both long and short hair in controlled environments, offering a wide range of styles and colours available for next-day delivery.
Mirrors & Whiteboards
Hygienic cleanroom mirrors are perfect for sensitive environments like cleanrooms and food production areas, eliminating contamination risks from broken glass. Made from stainless steel, these mirrors meet strict food industry standards and are easy to clean, ideal for sectors such as dairy and meat processing.
Particle Counters
Our handheld particle counter is perfect for routine on-site checks and environmental monitoring in cleanrooms. It’s user-friendly, easy to set up, and comes with a full validation certificate and carry case. Fully compliant with the latest ISO 14644 standards, it’s ideal for ISO and GMP cleanrooms.
Cleanroom Transfer Hatches
Explore our selection of cleanroom stainless steel and TRESPA transfer hatches. These pass-through hatches are highly customisable with a variety of options. Don’t worry—we’re here to guide you through every step of the specification and design process.
… And more
In addition, we manufacture a range of robust, high-quality stainless steel furniture and chairs designed for cleanroom and laboratory use. For projects requiring a tailored approach, our Custom Design service can create bespoke solutions to meet your exact specifications. Our product range also includes PPE and asbestos removal consumables, serving not only the cleanroom sector but also clients in construction, food production, and other industries with high hygiene requirements.
From our well-stocked warehouse, we ship worldwide and offer UK next-day delivery on most items, so you can rely on fast, dependable service. Explore our free PDF catalogue or consult our ISO 14644 Cleanroom Guide for expert insights.
Our friendly, knowledgeable staff are always ready to assist—contact us today to find the right solutions for your cleanroom or laboratory.
Images









































































